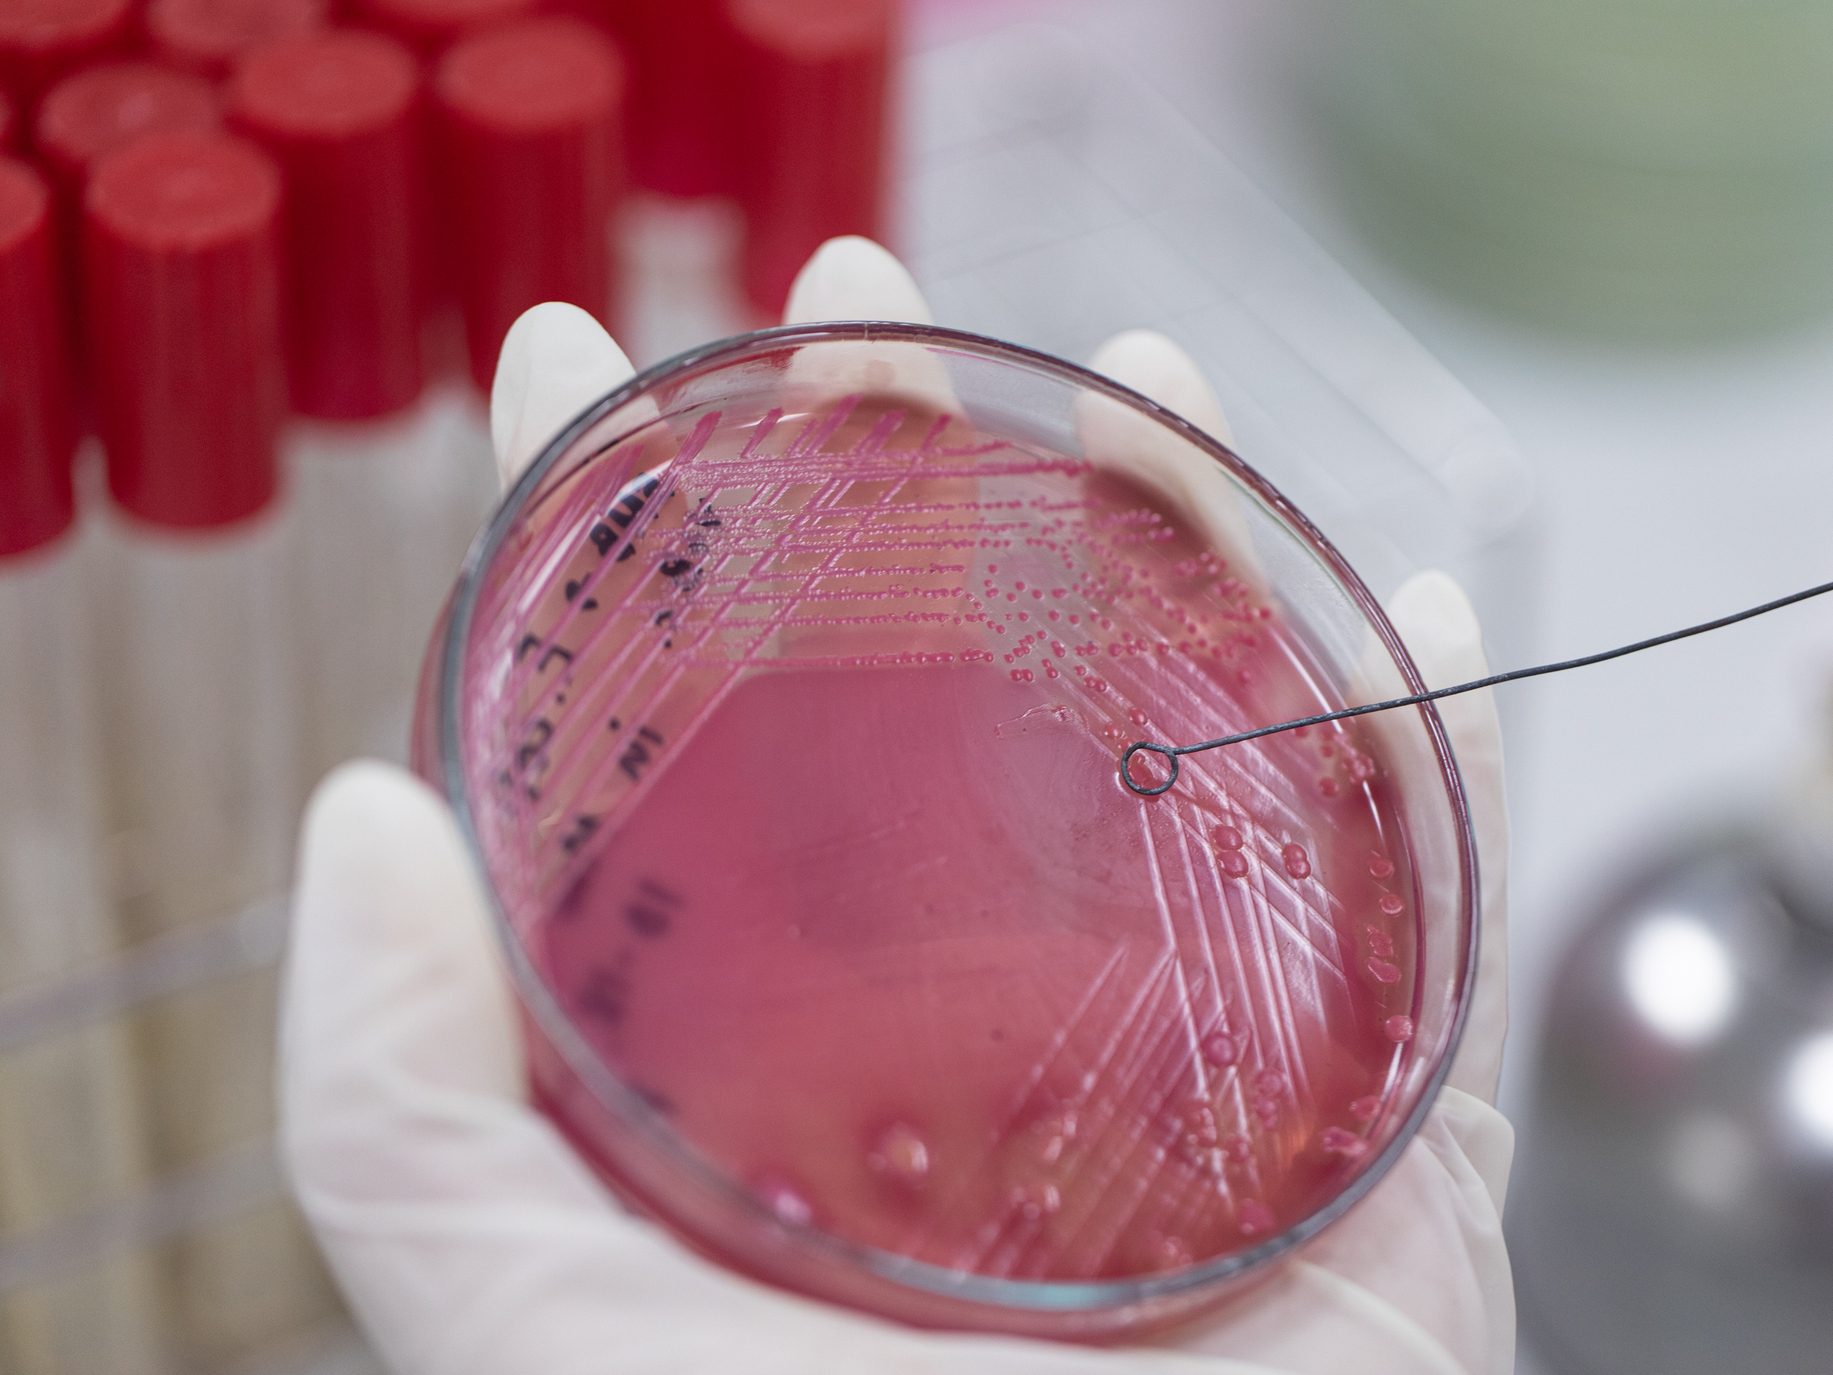
Michigan Medicine: New Warnings About Superbugs

Anastasia Wasylyshyn, M.D., of the division of infectious disease at University of Michigan Health explains
Author | Kelly Malcom, Michigan Medicine
The Centers for Disease Control and Prevention and the World Health Organization recently issued new, dire warnings about the spread of so-called superbugs, infectious bacteria for which there are no effective antibiotics.
Anastasia Wasylyshyn, M.D., of the division of infectious disease at University of Michigan Health talks about what superbugs are, how clinicians are fighting them and what you can do as a patient to help.
What are superbugs?
Superbugs are a category of germs that produce what we call carbapenemases, enzymes that bacteria produce to outsmart our antibiotics.
Meaning that even with our strongest, broadest spectrum antibiotics, they have figured out a way around them to survive.
What’s most concerning is that these bacteria have specific genes, like NDM, OXA, KPC, and VIM, that they are able to share with each other within a patient’s gut.
And so, you can have bacteria acquire resistance relatively quickly, unless we take the appropriate precautions to keep the bacteria in check.
How do you become infected with these superbugs?
These really bad gram-negative bacteria tend to be affiliated with health care settings, including hospitals, rehabilitation centers, nursing homes and hospitals abroad.
So, they are something you or a loved one might be exposed to if you are in and out of a lot of different hospitals.
What’s driving the increased spread of superbugs?
Unfortunately, increased use of antibiotics, both here and especially abroad where antibiotics are often available over the counter, are one of the main things driving antibiotic resistance.
How do infection control specialists fight against superbugs?
Within a hospital setting, clinicians who are making rounds will often wear gloves, gowns and masks to help keep the bacteria from a patient on that patient and avoid spreading bacteria around the facility.
Then there’s several cleaning practices that are integral to how hospital facilities work, including ensuring the right clearing agents are being used to kill bacteria as well as tools such as vaporized hydrogen peroxide to clean the most surface area possible in a hospital room after a patient is discharged.
Those practices are combined with antibiotic stewardship, which means determining the best antibiotics to use for a given patient’s infection, using cultures from the patient.
But sometimes people have these incredibly resistant organisms where there’s no single antibiotic that will work, which is pretty terrifying.
Sometimes we can still outsmart the bacteria by using a couple of antibiotics together to overwhelm the bacteria and kill it.
What about developing new antibiotics?
There are antibiotics that are in the pipeline and in development to more specifically target these extremely drug-resistant bacteria, but it’s a tricky situation for drug companies.
The incentives aren’t there to invest a bunch of money into research and development for an antibiotic that will rarely be used by infectious disease clinicians except in severe circumstances.
So, I think it’s hard to get new antibiotics on the market.
Because of this, there’s a lot of research into repurposing antibiotics that we have or combing through our existing drug library for things that may work against these incredibly resistant organisms.
What can you do as a patient to protect against superbugs?
The best piece of advice is if your doctor is telling you that you don’t need antibiotics for X, Y, Z health concerns that you have, please listen to that.
The more time you spend off of antibiotics, even if you’ve gotten a lot of antibiotics in the past, the more your normal microbiome can re-establish itself and outcompete these superbugs.
It’s also totally okay to ask your doctor to wash their hands when they come into the hospital or clinic room or say, ‘Hey, I didn’t see you use hand sanitizer; could you, just for my peace of mind?’
Do you have any more advice for stopping the spread of superbugs?
Beyond using good cleaning practices, facilities who may be worried about seeing more of these infections can reach out to the state department of health for real-time genetic sequencing to help tease out what may be happening.
Historically, there has been a push in the United States to address increased antibiotic resistance by The Joint Commission and other groups.
But, bottom line, control is about ratcheting in antibiotic use as much as we can.
You can read the original article here.

8123 Main St Suite 200 Dexter, MI 48130
8123 Main St Suite 200 Dexter, MI 48130


